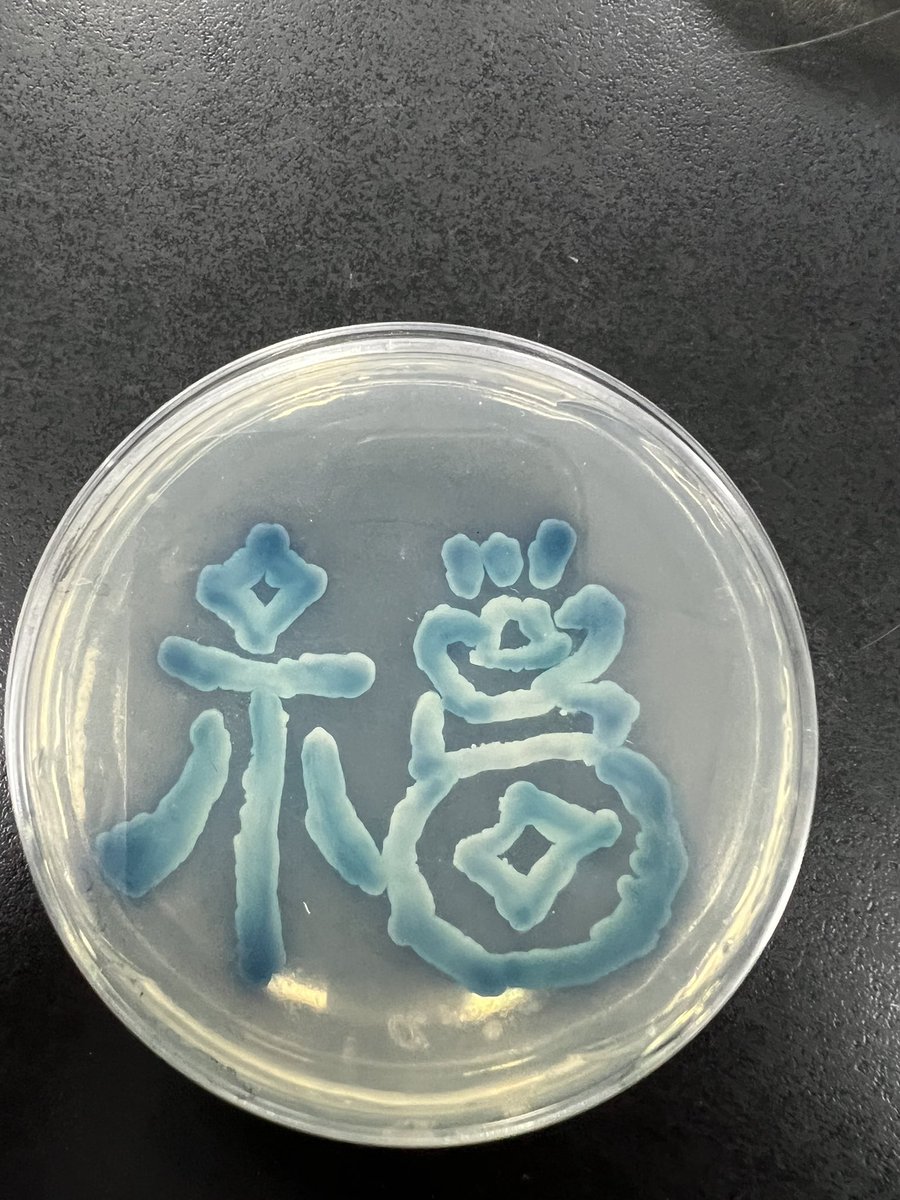

加了冰的冷萃咖啡
c391ce110e7fc1d4ea0037721fa0197d4797c895070c6c4fc0574040acb4596a
多读书多看报 少吃零食多睡觉。
是捏!很喜欢木吉这样的铁心真的内核好稳 https://t.co/36cQr0B64j

我心里没事了我真的好了
我真可笑。
笑死了我初中总干这事儿
明天就要放假噜,其实也有点舍不得实验室呢🔬
刚才见证了科室里两个女老师的塑料姐妹情🤣
我种的菌长出来了!!!感觉这个蓝色最好看🥳🥳🥳🥳🥳🥳 https://t.co/wOdApQRoM2
我妈已经打了四个电话了,给我妹排了好多课,可怜的高中生今天放假明天就去上课🤯
哎哟我有时候真的特讨厌老师这个群体。
我真的好喜欢小丑女和小丑男 https://t.co/E9l7dCDdsD 
时刻提醒自己飞醋要少吃
去你丫的实习,还我朋友! https://t.co/EYiXG6Uoqt 
我连着逃了好多天课了
今晚坐了一个从来没做过的城际公交回家,路过了一片荒岭,原本没什么稀奇的,但是它让我回想起大三的时候和我的密友们周末开车去看碉堡遗址的那片坡地,实在是太像了。我们最后去吃了一家特别香的烤蔬菜,那里的烤豆角和烤筋皮是朋友们的味道。
在细菌室种细菌玩了一下午✌🏾
希望明天能长出来!!!!! https://t.co/X7H3LcgXBA 
明天想去做头发,发现我那tony根本排不上了🥲
本来中午不想吃饭了上推刷几条就饿了
来姨妈想创死全世界
我喜欢Green!!!!!
